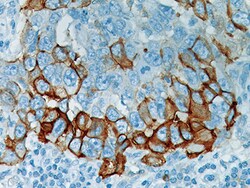
Biocare Medical, LLC PHOSPHO-EGFR Antibody - Predilute, 6.0 ml, Quantity:

Learn More
Biocare Medical, LLC PHOSPHO-EGFR Antibody - Predilute, 6.0 ml


Supplier: Biocare Medical, LLC API300AA

Epidermal Growth Factor Receptor antibody (EGFR) is a transmembrane glycoprotein receptor tyrosine kinase and is activated by EGF. The carboxy terminal tyrosine residues on EGFR, Tyr1068, Tyr1148 and Tyr1173 are major sites of autophosphorylation, which occurs as the result of EGF binding. Once activated, phosphotyrosines mediate the binding of growth factor receptor-binding protein-2 (Grb2) to the EGFR. This antibody only detects EGFR phosphorylated on Tyrosine 1068 of the mature human isoform. Over-expression of EGFR has been reported in tumors of breast, lung, colon, cervix, ovary, esophagus and endometrium.
By clicking Submit, you acknowledge that you may be contacted by Fisher Scientific in regards to the feedback you have provided in this form. We will not share your information for any other purposes. All contact information provided shall also be maintained in accordance with our Privacy Policy.